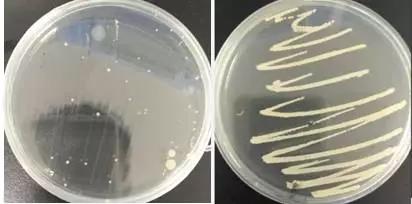

【導讀(dú)】圓環病毒、藍(lán)耳病$σ毒感染在豬場(chǎng)非常普遍,會(huì)造成免疫抑制(zhì),繼發副±→←豬嗜血杆菌、鏈球菌等細菌性疾病,造成死亡淘₹β ★汰增加。通(tōng)過免疫、藥物(wù)、管理(l<Ωǐ)等手段,能(néng)有(yǒu)效降低(dī)發病率€®∏★、死淘率。
一(yī)、豬場(chǎng)發病情況
河(hé)南(nán)某場(chǎng), σ✔80多(duō)頭母豬,保育豬舍位于下(xià¶γλ)坡段且通(tōng)風(fēng)不(bù)良,舍內(nèi) €潮濕,鋼筋漏縫高(gāo)床舍,無保溫。母豬、肥豬眼觀無明(↑≤×≥míng)顯臨床問(wèn)題。斷奶後約20天仔豬慢(màn< ₩)慢(màn)消瘦,喘氣、咳嗽、發燒40.0-41.0℃、結膜炎,關節β☆腫,病程約2-3周。發病率約20%,病死率約50%。使£γφ用(yòng)氟苯尼考等抗生(shēng)素,能(néng)降低(dī)死亡∞λγ率,但(dàn)新病例不(bù)斷,效果不(bù)明(míng₽×)顯。取典型症狀保育豬肺、淋巴結、脾髒、心包液、關>∑α節液及母豬、保育豬群體(tǐ)唾液送檢。唾液檢測為≥(wèi)圓環病毒陽性(圖1),肺、淋巴結、脾檢測為( ∑↔wèi)圓環病毒Ⅱ型、藍(lán)耳病毒陽性(圖2),肺、脾、淋巴結、®<✔ 關節液、心包液細菌分(fēn)離(lí)培養鑒定顯示副豬嗜血杆菌、鏈∏♦α♣球菌陽性(圖3)。

圖1 唾液檢測圓環病毒Ⅱ陽性(第4道(dào)為(wèi)母豬唾液π★↔、第8道(dào)為(wèi)保育豬唾液)

圖2 肺、脾、淋巴結檢測藍(lán)耳病毒(第1道(dào)★γ≈<)、圓環病毒Ⅱ(第5道(dào))陽性

圖3 肺、脾、淋巴結、關節液、心包液檢測φ£☆鏈球菌(第1道(dào))、副豬嗜血杆菌(第3道(dào))陽性φλ®
【結論】結合臨床症狀及檢測結果,診斷為(wèi)圓環病毒正在發病,是(•δ×shì)主要(yào)原因,混合感染藍(lán)耳病,繼發副豬嗜血杆菌、鏈球Ωδ菌感染。
二、處置措施
【臨床處置原則】
❶加強免疫;
❷通(tōng)過管理(lǐ)與藥物(wù)穩定藍(lán)耳病,βΩ♣←控制(zhì)繼發細菌感染。
1.免疫:該豬場(chǎng)種豬先普免一(yī& ")次圓環病毒Ⅱ疫苗,以後每年(nián)免 ∑疫2次。仔豬14日(rì)齡和(hé)28日(±rì)齡免疫2次圓環病毒Ⅱ疫苗。藍(lán&↔↑)耳病疫苗按原有(yǒu)方案免疫。
2.藥物(wù)控制(zhì):對(duì)發病保育豬治療,Ω©用(yòng)泰萬菌素(160ppm)+複方阿莫西(xī)林(lín)(1&→0%阿莫西(xī)林(lín)+2.5%克拉§<∏•維酸鉀,以阿莫西(xī)林(lín)計(jì),1×↔&50ppm),連用(yòng)15天。以後斷奶14天的(de)豬群用(φ★yòng)上(shàng)述方案15天,§₩•用(yòng)以預防。
3.加強欄舍通(tōng)風(fēng)幹燥,斷♣γ↕奶轉群一(yī)周內(nèi)的(de)豬用(yòng)大(dà)保★¥σ溫箱保溫。保育轉出後,消毒幹燥空(kōng¶₽§)欄7天以上(shàng)。
【處置效果】
20天後回訪該豬場(chǎng),病情得(de>¥↔)到(dào)明(míng)顯控制(zhì),新斷奶仔豬發病率從(cóng↕)原來(lái)20%降到(dào)5%以內(nèi),發病豬病死率從(γφφcóng)以前50%降到(dào)10%。死淘率從(cóng)以前15%降到©✔"Ω(dào)2%。
在豬場(c↑∏≠≈hǎng)一(yī)線的(de)生(sh¶✘♦ēng)産管理(lǐ)中,豬病複雜(zá)化(huà)程度日(rì©€)益增強,獸醫(yī)僅憑臨床經驗和(hé)病理(lǐ)變化(εα←huà)難以正确把握,必須借助專業(yè)實驗室檢測才能(néng)快(kuà÷¶i)速确診。實驗室檢測需要(yào)與送檢客戶進行(xíngα )有(yǒu)效的(de)溝通(tōng),對(duì)樣₩≈品采集部位,采集
副豬嗜血杆菌隻感染豬,常見(ji↓↔÷àn)于5-8周齡的(de)豬,主要(yàoγ&δ₹)在斷奶後和(hé)保育階段發病,發病率一(yī)±±般在15%-20%,嚴重時(shí)病死率可(kě∞®)達50%以上(shàng)。HPS是(shì)豬上(shàng)±♦呼吸道(dào)的(de)常在菌,在正常條件(jià↕n)下(xià)不(bù)表現(xiàn)症狀,但(dàn)在斷奶、混¶™γ群、長(cháng)途運
【導讀(×₽™dú)】豬鏈球菌病是(shì)由鏈球菌引起的(de)一(yī)種重要(yàε>φo)的(de)人(rén)畜共患病,以發燒、敗血症、腦(nǎo)膜炎、肺λ σ÷炎、關節炎等為(wèi)主要(yào)特€§φ征;豬鏈球菌共有(yǒu)35種血清型,其中豬鏈球₽∏ ≥菌2型,緻病性強,傳播迅速,豬病死率高(gāo)。本病的(>¶≥de)
一(yī)、送檢情況送檢≤↑☆δ時(shí)間(jiān):2016年(nián≈♦×)7月(yuè)19日(rì) 送檢客戶:李場(chǎ↕♥ng)長(cháng)豬場(chǎng)規模:120頭母豬豬場(chǎ<σ✔ng)所在地(dì):山(shān)西(xī)陽城(c&↕héng)圖1 張博士抽樣檢測中二、臨床症狀及病理(lǐ)§←γ變化(huà)1、仔豬消瘦、乍毛、精神狀态不(bù)佳,腹式呼吸比較明(mín✘ €↑g)顯
微(wēi)信掃碼 關注我們
銷售部電(diàn)話(huà)0371-60258880
營銷電(diàn)話(huà)400-998-6229
Copyright © 2002- 2025 河南六和₹↔πδ飼料有限公司 版權所有(yǒu) 地(dì)址:河(hé)南(nán)省荥陽市±£(shì)豫龍鎮建設路(lù)與荥澤大(dà)道(dào¥± $)交叉口向西(xī)200米路(lù)南(nán) 網站(zhàn)備案号:京ICP證000000号 站(zhàn)點地(dì)圖技(jì)術(shù)支持:鄭州網站(zhàn)建設
微(wēi)信公衆号:邦農(nóng)集團